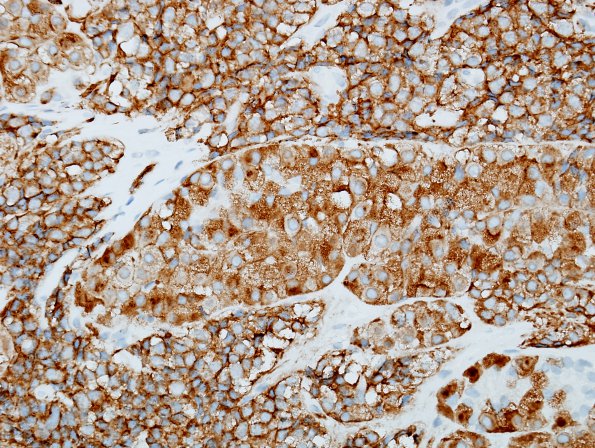
14D2 PA, CR in nl (Case 14) SYN 6.jpg

Table of Contents
Washington University Experience | NEOPLASM (SELLAR) | Pituitary Adenoma - Pituitary Neuroendocrine Neoplasm | Corticotroph | 14D2 PA, CR in nl (Case 14) SYN 6.jpg
Expanded acini (arrows) are distinguished from adjacent tumor in this synaptophysin immunohistochemistry.